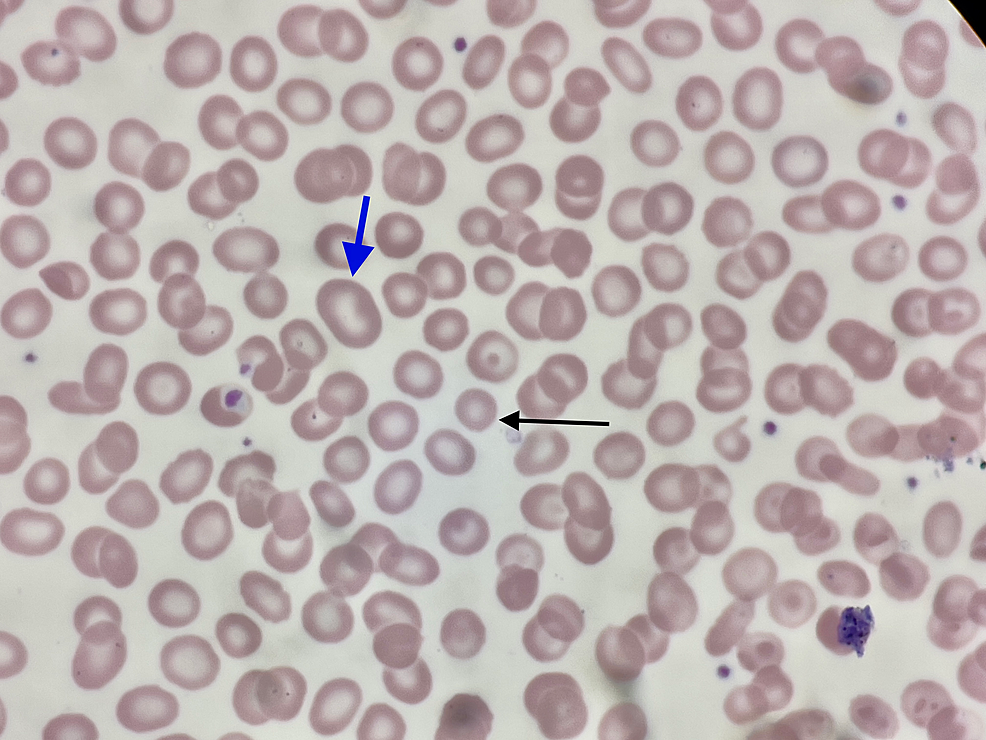
Peripheral blood smear: microcytic, normocytic, macrocytic

Erythrocyte Basics - Red Cell Roundup
- Biconcave, anucleated discs; ~7-8 µm diameter. Lifespan: ~120 days. 📌 Mnemonic: RBCs = Biconcave, Elastic, Anucleated Discs.
- Shape (spectrin); flexible for capillary passage. Energy: Anaerobic glycolysis.
- Normal count: Men 4.5-5.5 million/µL; Women 4.0-5.0 million/µL.
- Erythropoiesis (RBC production):
- Stimulus: Erythropoietin (EPO) from kidneys (hypoxia).
- Sites: Bone marrow (adults); Yolk sac, liver, spleen (fetus).
- Maturation: ~7 days. Key stages in marrow: Proerythroblast → Normoblast (nucleus loss) → Reticulocyte.
- Destruction: Macrophages in spleen ("RBC graveyard"), liver, bone marrow.

⭐ Reticulocyte count (normal: 0.5-2.5% of RBCs) is a crucial indicator of bone marrow's erythropoietic response.
Hemoglobin Details - Oxygen's Best Friend
- Structure: Quaternary; 4 globin chains + 4 heme groups (Iron $Fe^{2+}$ + Porphyrin).
- HbA ($α_2β_2$): >95% (Adult)
- HbA2 ($α_2δ_2$): 2-3.5%
- HbF ($α_2γ_2$): <2% (in adults); ↑ $O_2$ affinity.
- Function: $O_2$ transport (oxyHb), $CO_2$ transport (carbaminoHb ~20-25%), buffer (histidine residues).
- Oxygen Binding: Cooperative; 1 Hb binds 4 $O_2$ molecules, increasing affinity with each $O_2$ bound.
- $P_{50}$: $O_2$ tension for 50% saturation (Normal: 26.6 mmHg).

-
ODC Shifts: 📌 CADET, face Right! (CO2, Acid, 2,3-DPG, Exercise, Temp for right shift)
-
Key Derivatives:
- Carboxyhemoglobin (HbCO): CO affinity ~200-250x > $O_2$. Cherry-red appearance.
- Methemoglobin (MetHb): Iron in $Fe^{3+}$ (ferric) state, no $O_2$ binding. Chocolate-brown blood. ⭐ > Methemoglobinemia: $Fe^{2+}$ in heme is oxidized to $Fe^{3+}$. Causes include nitrites, dapsone, local anesthetics. Presents with cyanosis and chocolate-brown blood. Treatment: Methylene blue.
-
Normal Values (g/dL):
- Male: 13.5-17.5
- Female: 12.0-15.5
RBC Indices & Anemia - Count & Classify
-
RBC Indices: Essential for classifying anemias.
- MCV (Mean Corpuscular Volume): Avg RBC size. $MCV = (PCV / RBC \text{ count}) \times 10$. Normal: 80-100 fL.
- Microcytic: <80 fL
- Normocytic: 80-100 fL
- Macrocytic: >100 fL
- MCH (Mean Corpuscular Hemoglobin): Avg Hb weight per RBC. $MCH = (Hb / RBC \text{ count}) \times 10$. Normal: 27-32 pg.
- MCHC (Mean Corpuscular Hemoglobin Concentration): Avg Hb conc. in RBCs. $MCHC = (Hb / PCV) \times 100$. Normal: 32-36 g/dL.
- Hypochromic: <32 g/dL
- Normochromic: 32-36 g/dL
- RDW (Red Cell Distribution Width): RBC size variation (anisocytosis). Normal: 11.5-14.5%. ↑ in IDA, megaloblastic.
- MCV (Mean Corpuscular Volume): Avg RBC size. $MCV = (PCV / RBC \text{ count}) \times 10$. Normal: 80-100 fL.
-
Anemia: ↓ Hb or RBC count. WHO: Hb < 13 g/dL (M), < 12 g/dL (F non-preg).
-
Morphological Classification of Anemia:
⭐ RDW is often the first index abnormal in early IDA, before MCV ↓ or anemia.
Iron Metabolism - The Heme Engine
- Absorption: Duodenum (DMT1). Fe²⁺ (ferrous) absorbed; Vit C enhances. Ferroportin exports from enterocytes.
- Transport: Transferrin (plasma protein) transports Fe³⁺. TIBC reflects transferrin.
- Storage: Ferritin (main, soluble), Hemosiderin (insoluble, overload).
- Regulation: Hepcidin (liver peptide) = key negative regulator.
- Degrades ferroportin: ↓ absorption & ↓ macrophage iron release.
- Utilization: Ferrochelatase adds Fe²⁺ to protoporphyrin IX → Heme (mitochondria).
- Loss: Cell desquamation, minor bleeding. No active excretion.

⭐ Hepcidin, ↑ by inflammation (IL-6), causes iron sequestration leading to anemia of chronic disease.
High‑Yield Points - ⚡ Biggest Takeaways
- Erythropoiesis needs iron, B12, folate; EPO (kidneys) is key stimulus.
- RBC lifespan is ~120 days; spleen handles destruction.
- Hemoglobin (Hb): 4 globin chains, 4 heme groups; each heme binds O2.
- O2-Hb curve shifts right (↓O2 affinity) with ↑CO2, ↑H+, ↑2,3-DPG, ↑temperature.
- HbF (α2γ2) has higher O2 affinity than HbA (α2β2), facilitating fetal oxygen uptake.
- Iron absorption in duodenum, regulated by hepcidin; deficiency causes microcytic anemia.
Continue reading on Oncourse
Sign up for free to access the full lesson, plus unlimited questions, flashcards, AI-powered notes, and more.
CONTINUE READING — FREEor get the app